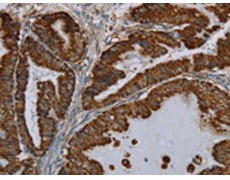
一抗

反應(yīng)種屬: Human
標(biāo) 記 物: Unconjugate
Background:
17β-HSD2 (17β hydroxysteroid dehydrogenase type 2) belongs to the 17β-HSD family of proteins that regulate the availability of steroids within a tissue. 17β-HSD2 converts active steroids to their inactive form through its oxidative activity. It is a key player in the inactivation of Estradiol and testosterone. Due to the affects that 17β-HSD2 has on the availability of estrogen, it has been extensively investigated for playing a possible role in breast tumor development, colon cancer development and the pathophysiology of endometriosis.
Applications:
ELISA, WB, IHC
Name of antibody:
HSD17B2
Immunogen:
Fusion protein of human HSD17B2
Full name:
hydroxysteroid (17-beta) dehydrogenase 2
Synonyms:
HSD17; SDR9C2; EDH17B2
SwissProt:
P37059
ELISA Recommended dilution:
2000-5000
IHC positive control:
Human esophagus cancer and human brain
IHC Recommend dilution:
50-200
WB Predicted band size:
43 kDa
WB Positive control:
Human fetal liver tissue
WB Recommended dilution:
500-2000
技術(shù)規(guī)格




 購(gòu)物車
購(gòu)物車 幫助
幫助
 021-54845833/15800441009
021-54845833/15800441009